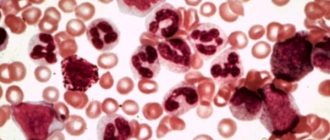

Господарство
Башкирська качка була виведена в Росії в 2001 році на племзаводі «Благоварский» шляхом відбору
Лейкоз корів – невиліковне захворювання інфекційного походження, відрізняється тривалим хронічним перебігом. Патологія супроводжується злоякісним
Для росту і швидкого розмноження кроликів необхідно забезпечити для них комфортні умови. Важливо знати,
Опис і особливості породи Бельгійська корова Бельгійська блакитна корова володіє незвичайною зовнішністю, за що
Поява неприємної гіркоти знижує смакові якості молока і призводить до зниження попиту на молочну
Нормативні вимоги по ГОСТ до зберігання продукту Перевірка яйця на свіжість Принципи зберігання продукту,
Дикі качки поширені повсюдно і полювання на них досить популярне явище. При цьому цілі
На сьогоднішній день виведено величезну кількість домашньої